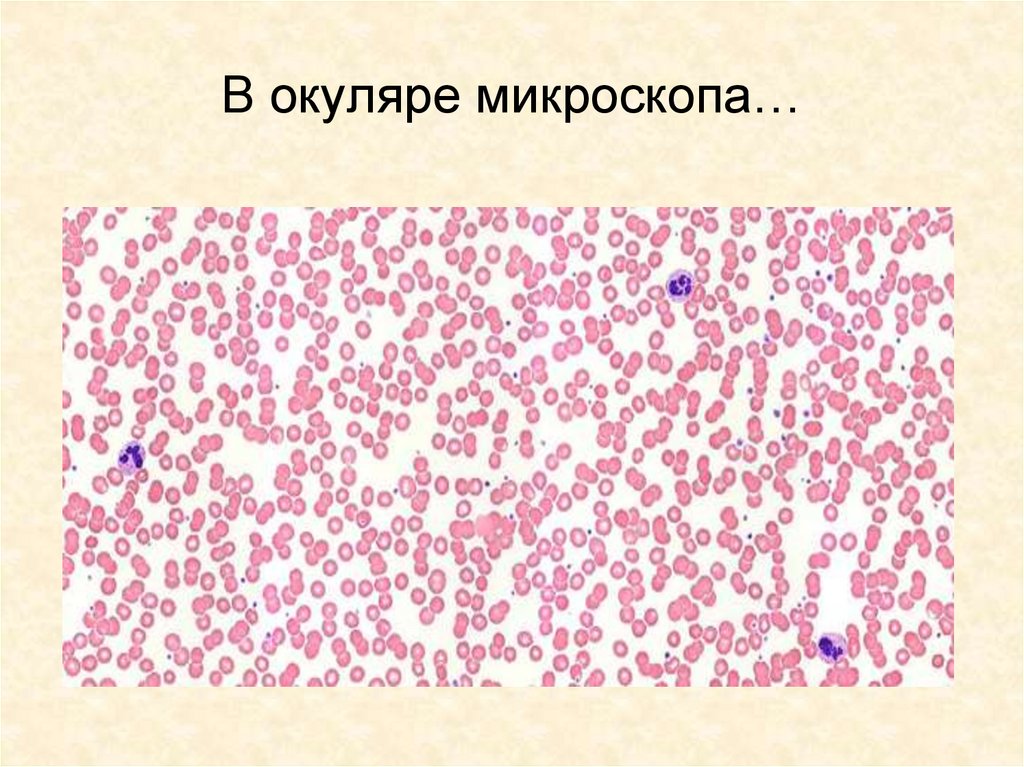

Похожие презентации:
Внутренняя среда организма. Кровь
1.
Внутренняя средаорганизма. Кровь
2. Значение крови:
• Взаимосвязь всех органов в организме;• Передвижение и распределение
питательных веществ между органами;
• Обеспечение газообмена между
клетками и окружающей средой;
• Удаление из организма вредных
продуктов обмена;
• Защита организма (иммунитет);
• Терморегуляция
3. Функции крови:
питательная —за счет транспорта растворенных питательныхвеществ от пищеварительного тракта к тканям, местам
резервных запасов и от них;
дыхательная — путем транспорта газов (кислорода и
углекислого газа) от дыхательных органов к тканям и в обратном
направлении;
транспорт гормонов от желез внутренней секреции к органам
(гуморальная регуляция);
транспорт конечных продуктов метаболизма из тканей к
органам выделения;
терморегуляторная — перераспределение тепла между
органами, регуляцию теплоотдачи через кожу;
механическая — придание тургорного напряжения органам за
счет прилива к ним крови, а также обеспечения
ультрафильтрации в капиллярах капсул нефрона почек и др.;
гомеостатическая — поддержание постоянства внутренней
среды организма, пригодной для клеток в отношении ионного
состава, концентрации водородных ионов и др.
защитная — обеспечение клеточного и гуморального
иммунитета, свертывания крови;
В оглавление
4. ДЕЛА КРОВАВЫЕ: (Краткая история переливания крови)
ДЕЛА КРОВАВЫЕ:(Краткая история
переливания крови)
5. Из истории
Дряхлый папа ИннокентийVIII пытался вернуть себе
молодость с помощью
вливания крови, взятой от
десятилетних мальчиков.
Мальчики погибли от
кровопотери, а вслед за
ними скончался и сам папа.
(Т.И. Грекова. Атеизм и
медицина. 1983)
6. 1667 — Жан Дени
1667 — Жан ДениПрофессор
из Монпелье,
переливает кровь
ягненка
душевнобольному.
Вскоре переливание
крови во Франции было
запрещено на 150 лет.
7. 1819 - Бландем
Остались воспоминанияодной из первых
пациенток, потерявшей
много крови при родах
и получившей затем
четверть литра донорской
крови. По её словам, она
ощутила, „будто сама
жизнь проникает
в её организм“.
8. 1901 – Пауль Эрлих и Карл Ландштейнер
Почему в одних случаях чужаякровь отлично «приживается» в
организме нового «хозяина» и
спасает ему жизнь, а в других
разрушается и вызывает
тяжелую, подчас смертельную
реакцию? На эти вопросы в
начале XX в. дали ответ
немецкий ученый П.Эрлих и его
ученик- австриец К.
Ландштейнер, открыв три
группы крови, а затем чешский
ученый Я. Янский открыл еще и
IV группу крови.
Таким образом, все население
земного шара имеет 4 разные
группы крови.
В оглавление
9.
10.
КровьЛимфа
Тканевая
жидкость
11.
Кровь движется позамкнутым сосудам и
непосредственно с
клетками не
контактирует.
Тканевая жидкость
образуется из жидкой
части крови.
Лимфа образуется из
тканевой жидкости.
12.
Поддержаниеотносительного
постоянства
состава внутренней
среды организма
называется
13. В организме человека примерно 5-6 литров крови
14.
КровьПлазма
60%
Форменные
элементы
Эритроциты
Тромбоциты
Лейкоциты
15.
Плазма кровиНеорганические вещества
Органические вещества
Белки,
аминокислоты
Вода
Минеральные
Глюкоза
соли 0,9%
Витамины
Жировые
вещества
Продукты
распада
Гормоны
16. Функции плазмы крови:
• Распределение питательных веществпо организму;
• Удаление из организма вредных
продуктов обмена веществ;
• Участие в свёртывании крови (белок
фибриноген)
17.
18.
КРОВЬПЛАЗМА
Форменные
элементы
ЭРИТРОЦИТЫ
ЛЕЙКОЦИТЫ
ТРОМБОЦИТЫ
19.
20.
Эритроциты21. Форменные элементы крови
Форменныеэлементы
Эритроциты
Количество
в 1мм3
5млн.
Продолжитель
ность
жизни
120
дней.
Строение
Где
образуются
Функции
Двояковогнутый
диск, снаружи
Красный Перенос
покрыт
костный кислорода
мембраной,
мозг
и углекисвнутри
лого газа
содержится
гемоглобин, нет
ядра.
22. В окуляре микроскопа…
23. Кровь в пробирке
24.
Газообмен между легкими икровью
25.
Газообмен между кровью итканями
26. Строение и виды гемоглобина
ГлобинБелковая часть гемоглобина
Гем
Небелковая часть гемоглобина
Оксигемоглобин Непрочное соединение
гемоглобина с кислородом,
образуется в органах дыхания
Миоглобин
Дыхательный пигмент,
идентичный гемоглобину,
содержится в мышцах,
обеспечивает снабжение
работающих мышц кислородом
27.
28.
Транспортируют кислороди углекислый газ
Содержат гемоглобин
Присоединяя кислород,
гемоглобин превращается
в оксигемоглобин
29.
В 1 мм3 крови – до 5 млн.эритроцитов, т. е.
эритроциты очень мелкие –
больше их общая
поверхность
30.
Имеют формудвояковогнутого диска –
больше площадь
поверхности каждого
эритроцита
31.
Не имеют ядра –весь объем эритроцита
занимает гемоглобин
32. Созревание эритроцита
33. Влияние солевого состава среды на эритроциты
2,0%0,9%
0,2%
2,0% - гипертонический раствор
0,9% - физиологический раствор
0,2% - гипотонический раствор
34.
Лейкоциты35.
Форменные элементы кровиФорменные
элементы
Лейкоциты
Количество
В 1мм3
4-5
тысяч.
Продолжительность
жизни
Строение
Где
образуются
От
нескольких
часов до 10
дней.
Форма
непостоянна,
состоят из ядра
и цитоплазмы.
Функции
Красный
костный
мозг.
Защита
Лимфотиче
.
ские узлы
36. Лейкоциты
ВидыЗернистые
Незернистые
Нейтрофилы
Лимфоциты
Эозинофилы
Моноциты
Базофилы
37.
ЛЕЙКОЦИТЫЛИМФОЦИТЫ
В - клетки
Т - клетки
Антитела
Особые вещества
соединяются
с бактериями
и делают их
беззащитным
и против
фагоцитов
вызывают
гибель
бактерий и
вирусов
Иммунная реакция
ФАГОЦИТЫ
Фагоцитоз
38.
В 1 мм3 крови – 4 -5 до 9 тыс.лейкоцитов
Лейкоциты имеют цитоплазму
и ядро
39.
Виды лейкоцитова) Гранулоциты - лейкоциты,
содержащие в цитоплазме зерна
(гранулы). Защищают организм от
бактерий и токсинов
40.
Виды лейкоцитовб) Лимфоциты - лейкоциты,
обеспечивающие иммунитет
41.
Мечников Илья Ильич (1845 – 1926 гг.)Выдающийся биолог и патолог. В
1883г. Открыл явление
фагоцитоза.
В 1901г. В своем знаменитом
труде «Невосприимчивость в
инфекционных болезнях»
изложил фагоцитозную
теорию иммунитета.
Создал теорию происхождения
многоклеточных организмов,
занимался проблемой старения
человека.
В 1998г. Удостоен Нобелевской
премии.
42.
МечниковИлья Ильич
в) Моноциты (фагоциты)
(1845 - 1915)
захватывают инородные тела с
помощью ложноножек и пожирают их
43. Иммунитет
Иммунитет (лат. immunitas — освобождение,избавление от чего-либо) —
невосприимчивость, сопротивляемость
организма к инфекциям и
инвазиям чужеродных организмов (в том числе
— болезнетворных микроорганизмов), а также
воздействию чужеродных веществ
44. Иммунитет
ИммунитетЕстественный
(природный)
Врождённый
Искусственный
(приобретённый)
Приобретённый
(после болезни)
Пассивный
( с молоком матери)
Пассивный
(после введения
лечебной сыворотки)
Активный
(после болезни)
Активный
(после вакцинации)
45.
46.
47.
ПиноцитозФагоцитоз
48.
Пиноцитоз – поглощениеклеткой капелек жидкости.
Фагоцитоз – поглощение
клеткой твердых частиц
( возможно в роли частиц
выступление бактерий и
вирусов)
49.
Тромбоциты участвуют вобразовании тромба –
в них содержатся
ферменты, необходимые
для превращения
фибриногена в фибрин
50.
Форменные элементы кровиФорменные
элементы
Тромбоциты
Количество
В 1мм3
200-400
тысяч.
Продолжитель
ность
жизни
8-10
суток.
Строение
Фрагменты
крупных
клеток
костного
мозга.
Где
образуются
Функции
Красный
костный
мозг.
Свертывание
крови.
51. Образование тромба
Растворимый белок фибриноген превращается в нерастворимыйбелок фибрин:
Фибриноген + Са2+
Ферменты
тромбоцитов
Фибрин
52.
Тромбоциты53. Строение тромба
сыворотканити фибрина
эритроциты
лейкоциты
54.
Ранение кровеносных сосудовПротромбин
Тромбопластин + Са
+ О2
Тромбин
Фибриноген
Фибрин
55. Фибриноген в крови
56. Тромб
57.
58. О чем расскажет капля крови?
Анализ крови — один из наиболеераспространённых методов
Медицинской диагностики.
Всего лишь несколько капель крови
позволяют получить важную
информацию о состоянии организма.
При анализе крови определяют количество клеток крови,
содержание гемоглобина, концентрацию сахара и других веществ,
скорость оседания эритроцитов (СОЭ).Если в организме имеется
воспалительный процесс, то СОЭ увеличивается. Норма СОЭ для
мужчин 2-10 мм/ч, для женщин 2-15 мм/ч.
При снижении количества эритроцитов или гемоглобина в крови по
какой-либо причине у человека возникает длительное или
кратковременное малокровие.
59.
Лабораторная работа«Рассматривание крови человека и лягушки
под микроскопом»
Задания:
1. На препарате крови лягушки рассмотрите эритроциты.
2. Выясните, в чем их различие.
3. Зарисуйте эритроциты лягушки в тетради.
4. Рассмотрите препарат крови человека, найдите в поле
зрения микроскопа эритроциты.
5. Зарисуйте эти кровяные тельца в тетрадях.
6. Найдите отличия эритроцитов человека от эритроцитов
лягушки.
7. Чья кровь, человека или лягушки, перенесет в единицу
времени больше кислорода? Почему?
60.
61. Влияние алкоголя
62.
1. Внутреннюю среду организма образуют:А – кровь, лимфа, тканевая жидкость
Б – полость тела
В – внутренние органы
Г – ткани, образующие внутренние органы
63.
2. Жидкую часть крови называют:А – тканевой жидкостью
Б – плазмой
В – лимфой
Г – физиологическим раствором
3. Все клетки тела окружает:
А – лимфа
Б - раствор поваренной соли
В – тканевая жидкость
Г – кровь
64.
4. Из тканевой жидкости образуется:А – лимфа
Б – кровь
В – плазма крови
Г – слюна
5. Строение эритроцитов связано
с выполняемой ими функцией:
А – участием в свертывании крови
Б – обезвреживанием бактерий
В – переносом кислорода
Г – выработкой антител
65.
6. Свертывание крови происходит благодаря:А – сужению капилляров
Б – разрушению эритроцитов
В – разрушению лейкоцитов
Г – образованию фибрина
7. При малокровии в крови уменьшается содержание:
А – кровяной плазмы
Б – тромбоцитов
В – лейкоцитов
Г – эритроцитов
66.
8. Фагоцитоз – это процесс:А – поглощения и переваривания микробов
и чужеродных частиц лейкоцитами;
Б – свертывания крови
В – размножения лейкоцитов
Г – перемещения фагоцитов в тканях
9. Антигенами называют:
А – белки, нейтрализующие вредное действие
чужеродных тел и веществ
Б – чужеродные вещества, способные вызвать
иммунную реакцию
В – форменные элементы крови
Г – особый белок, называемый резус-фактором
67.
10. Антитела образуются:А – всеми лимфоцитами
Б – Т-лимфоцитами
В – фагоцитами
Г – В-лимфоцитами
68.
Тканевая жидкость – это компонентвнутренней среды, в котором непосредственно
находятся все клетки организма
Состав тканевой жидкости:
•Вода – 95%
•Минеральные соли – 0,9%
•Белки и другие органические
вещества – 1,5%
• О2
• СО2
69.
ЛимфаИзбыток тканевой жидкости попадает в вены и
лимфатические сосуды. В лимфатических
капиллярах она изменяет свой состав и
становится лимфой. Лимфа медленно движется
по лимфатическим сосудам и в конце концов
попадает снова в кровь. Предварительно лимфа
проходит через особые образования –
лимфатические узлы, где она фильтруется и
обеззараживается, обогащается
лимфатическими клетками.
Движение крови и тканевой жидкости в
организме
70. Система групп крови - АВО
Определяют группы крови поособым стандартным
сывороткам, получаемым
заранее из крови людей, у
которых уже установлена
группа крови.
Распределение групп
крови системы АВО в
России:
группа О(I) – 35 %;
группа А(II) – 35-40 %;
группа В(III) – 15-20 %;
группа АВ(IV) – 5-10 %.
71.
Агглютиногены вэритроцитах
Агглютинины в
плазме
I(0)
Отсутствуют
аиb
II(A)
А
b
III(В)
В
а
IV (АВ)
АиВ
Отсутствуют
Группа
крови
О
О
72. I группа крови
Заключение: группа крови – IУНИВЕРСАЛЬНЫЙ ДОНОР
К I (0) группе относится
кровь, эритроциты
которой не склеиваются
в плазме или сыворотке
других групп. Поэтому
кровь I группы можно
переливать всем
людям.
73. II группа крови
Заключение: группа крови - IIКо II (А) группе
относится кровь,
эритроциты которой
склеиваются и
разрушаются в плазме
или сыворотке крови I и
III групп. Кровь этой
группы совместима с
кровью II и IV групп, ее
можно переливать
только людям с этими
группами крови.
74. III группа крови
Заключение: группа крови - IIIК III (В) группе
относится кровь,
эритроциты которой
склеиваются и
разрушаются в плазме
или сыворотке крови I и
II групп, но совместимы
с эритроцитами III и IV
групп. Кровь этой
группы можно
переливать людям с
кровью III и IV групп.
75. IV группа крови
Заключение: группа крови – IVУНИВЕРСАЛЬНЫЙ РЕЦИПИЕНТ
К IV (АВ) группе
относится кровь,
эритроциты которой
склеиваются в плазме
или сыворотке всех
других групп. Кровь этой
группы можно
переливать только
людям, имеющим ту же,
IV, группу крови.
76. Схема переливания крови
77. Встречаемость групп крови:
Частота встречаемости в %Национальность
0(I)
A(II)
B(III)
AB(IV)
Русские
33
38
21
8
Литовцы
40
34
20
6
Грузины
55
29
10
6
Калмыки
26
22
41
11
Немцы
33–44
40–48
8–17
3–7
Англичане
45–53
30–43
8–12
2–4
Американски
е
индейцы
99–100
0,1–0,5
–
–
аборигены
47–63
32–48
0–10
0–3
Африканские
бушмены
56
33
9
2
Австралийские
В оглавление
78. Словарь терминов:
Агглютинины – антитела, вызывающие агглютинацию клеток идругих антигенных частиц
Агглютиноген - любой антиген, вызывающий образование
агглютинина в сыворотке крови
Агглютинация – слипание эритроцитов с антигенами под действием
плазменных (сывороточных) антител (агглютининов) с
образованием хорошо заметных скоплений (смотри по ссылке)
Донор – человек, отдающий свою кровь для переливания другим
людям или для хранения в банк крови
Антиген – любое вещество, которое определяет как чужеродное и
потенциально опасное для организма и против которого начинает
вырабатывать собственные антитела
Антитела – белки крови, синтезируемые лимфоидной тканью в ответ
на появление антигена
Реципиент – человек, получающий что-либо (кровь, органы) от
донора
На следующий слайд
В оглавление
79. Rh (резус) - фактор
Он впервые был обнаружен вкрови обезьяны – макаки-резус.
Примерно у 85% людей в
эритроцитах содержат белок –
резус-фактор, а 15% населения
его не имеют.
На качестве крови его отсутствие
не отражается, но его надо
учитывать при переливании крови
и при беременности.
80. Открытие резус - фактора
1937-1940 — уехавшийв США от нацистов Карл
Ландштейнер и его
коллеги: Александр
Винер и Филипп Левин
открыли резус-фактор,
за что были удостоены
Нобелевской премии.
81. Встречаемость резус-фактора:
Частота встречаемости в %Национальность
Резусположительные
Резус-отрицательные
Русские
86
14
Норвежцы
85
15
Арабы
72
28
Эскимосы
99–100
0–1
Мексиканцы
100
0
Американские
индейцы
90–98
2–10
Австралийские
аборигены
100
0
Китайцы
98–100
0–2
Японцы
99–100
0–1
Баски
64
В оглавление
36
82. Значение знаний о группах крови
Знание групп крови имеетобщеизвестное судебномедицинское значение:
а) определение группы
крови преступника, пятен
крови на месте
преступления и вещах
б) определение отцовства
в) Rh-значение при
беременности (резус
конфликт!)
К следующему
83. Определение группы крови преступника
Во время вооруженного нападения наинкассаторскую машину, одному из
преступников было причинено
огнестрельное повреждение, его кровь
была обнаружена на месте
преступления, изъята и сохранена в
надлежащих условиях. Спустя несколько
месяцев за попытку вооруженного
ограбления были задержаны ранее
судимые граждане В. и К. На основе
оперативных данных было выдвинуто
предположение, что В. и К. причастны к
нападению на инкассаторскую машину.
Проведенными генотипоскопическими
исследованиями было установлено, что
кровь на месте нападения на
инкассаторскую машину происходит от
гражданина К., вероятность ошибки один на восемьдесят миллиардов.
84. Определение отцовства
Один из наиболее распространенныхповодов для сомнений в биологическом
отцовстве - несовпадение групп крови. (Я ли
отец этого ребенка? У него группа крови
отличается и от моей и от группы крови
матери. Тут что-то не так.). Насколько
оправданы эти сомнения? Иногда оправданы,
но чаще всего - нет. Вообще, использование
системы группы крови для установления
родства является неэффективным, так как
вероятность случайного совпадения очень
высока. В Таблице показаны возможные
группы крови ребенка при различных
сочетаниях групп крови родителей. Однако в
ряде случаев и понимание наследования
групп крови помогает разрешить проблемы часто просто снять необоснованные
подозрения.
85. С помощью этой таблицы можно определить группу крови будущего ребенка, зная группу крови родителей. Красным цветом выделены
группы крови родителей. Напересечении, соответственно синим цветом - возможная
группа крови ребенка.
I
II
III
IV
I
I, II
I, III
II, III
I, II
I, II
I, II, III,
IV
II, III, IV
III
I, III
I, II, III,
IV
I, III
II, III, IV
IV
II, III
II, III, IV
II, III, IV
II, III, IV
I
II
86.
Rh – значение при беременностиОсложнения возникают том случае, если
_
женщина с кровью Rh вынашивает
плод, который унаследовал от отца
кровь группы Rh+. В этом случае в крови
реципиента вырабатываются иммунные
антирезус-агглютинины
(антитела),
вызывающие
агглютинацию
эритроцитов. Чудесным достижением
медицины
теперь
уже
прошлого
столетия стал способ профилактики
этого конфликта. Он состоит в том, что
сразу после родов женщине вводят
специальный препарат, содержащий
антирезус-антитела
и
быстро
разрушающий попавшие в её организм
резус-положительные эритроциты плода.
Тем самым предотвращается выработка
антирезус-антител у матери, что спасает
жизнь и здоровье её будущих детей.
87.
Резус - конфликтВ оглавление
88. Доноры и донорская кровь
Кровь есть у всех. Это такаяже ткань как и кожа, мышцы и
т.д.. Переливания крови от
одного организма -другому
(гемотрансфузия), это тоже
именно что и трансплантация пересадка тканей, только
процесс пересадки происходит
намного проще.
Слово «донор» происходит от
латинского donare — дарить.
То есть донор — это человек,
который дарит. В большинстве
случаев он дарит жизнь
14 июня - Всемирный день доноров
89. Есть несколько принципов, на которых основан институт "донорства крови":
Есть несколько принципов, накоторых основан институт
"донорства крови":
Во-первых - дело это сугубо добровольное
Донор может сдать кровь за деньги или бесплатно то есть даром
Кровь для лечебной цели может быть взята не
обязательно у человека
Донором может стать любой дееспособный
гражданин от 18 до 60 лет, прошедший мед.
обследование
И естественно если взятие крови не нанесет донору
вреда
90. Для того, чтобы стать донором, обязательны:
возраст от 18 до 60 лет;вес не менее 50 кг;
хорошее самочувствие.
Дозы взятия крови:
200 мл.
400 мл.
450 мл.
91. Причины временного отвода от донорства:
после ОРЗ – 1 месяц;после прививок – 1 месяц;
после удаления зубов – 1 месяц;
после операции, рождения ребенка – 1
год;
после татуировки или пирсинга – 1
год;
женщины не могут сдавать кровь во
время беременности и 1 год после
рождения ребенка
92. Причины постоянного отвода от донорства
перенесенные или имеющиеся вирусные гепатиты;заболевания крови;
имевшиеся гомосексуальные связи;
имевшиеся беспорядочные половые связи;
употребление, даже однократное, наркотиков
внутривенно (кроме условий стационара);
близорукость более 6 диоптрий;
психические заболевания;
алкоголизм и наркозависимость;
гипертоническая болезнь (высокое артериальное
давление).
В оглавление
93. Проверь свои знания:
1) Человек, отдающий свою кровь для переливаниядругим людям или для хранения в банк крови,
ДОНОРОМ
называется 2) Человек, получающий что-либо (кровь, органы) от
реципиентом
донора, называется 3) слипание эритроцитов с антигенами под действием
плазменных (сывороточных) антител (агглютининов) с
образованием хорошо заметных скоплений,
называется агглютинация
4) Всегда ли родители могут быть донорами для своих
детей?
5) С какого возраста можно сдавать донорскую кровь?
6) В каком случае между матерью и вынашиваемым ею
ребёнком может возникнуть резус - конфликт?
Рекомендуем по изученному материалу

Медицина
Медицина







